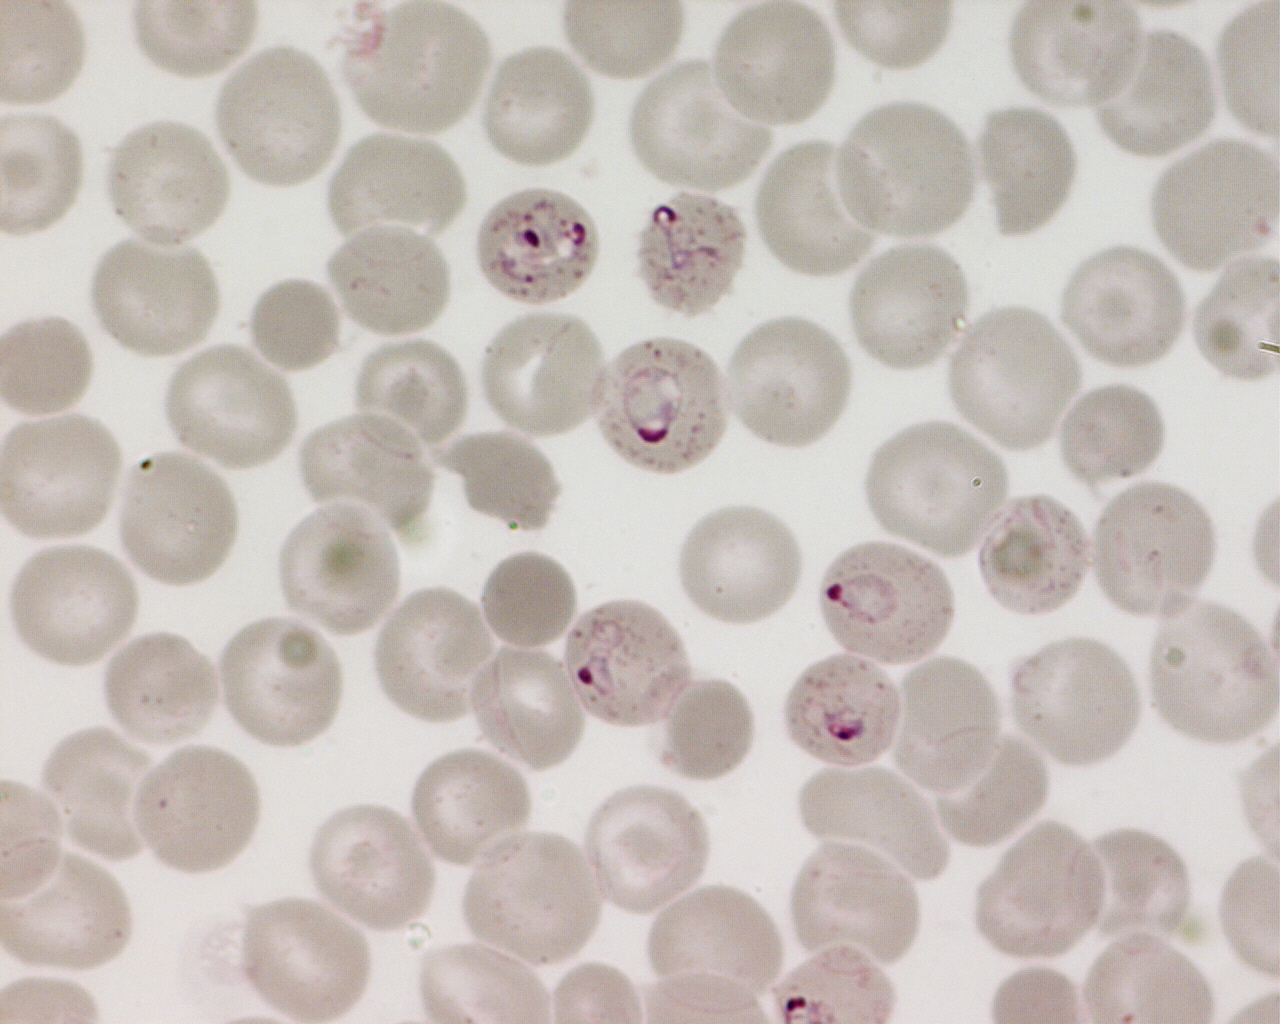
Pr paration Aux Concours De L internat Pharmacie

If you are having a hard time accessing the Rpn Pharmacie page, Our website will help you. Find the right page for you to go to Rpn Pharmacie down below. Our website provides the right place for Rpn Pharmacie.

https://www.wrizzle.ai › es › poem-generator
Crea poemas nicos y con rima al instante con nuestro generador de poemas Uso gratuito sin necesidad de registro
https://www.canva.com › es_mx › crear › creador-poemas
S lo tienes que decirle a nuestro generador de poemas qu es lo que te inspira y ver s c mo aparece texto que servir como punto de partida para tus haikus sonetos odas acr sticos y mucho m s

https://www.pensador.com › es › poemas_con_rimas
Sumergirse en poemas con rimas despierta la imaginaci n y toca el coraz n La musicalidad de las palabras desde las peque as reflexiones hasta las grandes

https://aibro.io › es › poetry
Crea poemas para rimar con palabras dadas en espa ol gratis con el chatbot de red neuronal IA online AiBro

https://www.culturagenial.com › es › poemas-cortos-con-rima
La rima que aporta ritmo y sonoridad a la poes a facilita la memorizaci n Al mismo tiempo esta semejanza de sonidos puede resultar muy divertida para los ni os A continuaci n te proponemos

https://www.parabebes.com
En este art culo de paraBeb s encontrar s los mejores poemas con rimas para ni os y ni as Cada uno de ellos te servir para pasarlo en grande mientras aprenden y se divierten

https://www.detectordeplagio.org › creador-de-poemas
AI creador de poemas te permite escribir poemas con rimas atractivos inspiradores y creativos al instante Es un generador de poemas online 100 gratis

https://mundoaprendiz.com › aprendizajes › poemas-con-rimas-para-ninos
Encuentra poemas con rimas para ni os de primaria que riman Poemas cortos y f ciles de aprender ideales para hacer que los ni os disfruten de la poes a

https://www.todopoemas.com › poemas-para-mi-hijo-cortos
En Todo Poemas te presentamos una selecci n de hermosos poemas para tu hijo llenos de amor y ternura Descubre estos cortos versos que expresan todo el amor y la felicidad que sientes al tener a
Thank you for visiting this page to find the login page of Rpn Pharmacie here. Hope you find what you are looking for!